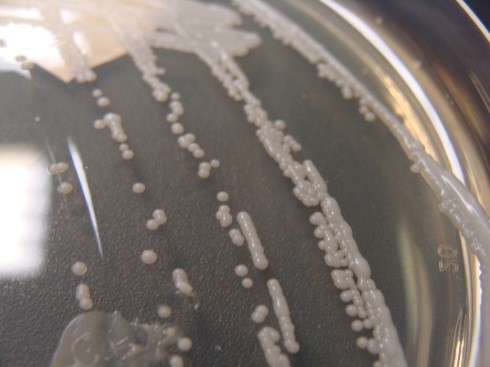

Faster identification of bacterial infections using Raman spectroscopy could save lives
Utilising a Renishaw Raman spectroscopy system, a team of researchers from the Czech Academy of Sciences have been testing a novel way to identify Staphylococcal bacteria, paving the way for faster diagnosis and treatment of infectious diseases.
Staphylococci are a type of bacteria commonly found on the skin and hair of humans and mammals. They are usually harmless, however some strains, such as Staphylococcus aureus (S. aureus), can cause more serious infections if they are able to enter the body. The management of patients with bacterial infections relies on the early detection and identification of pathogens, as it enables the appropriate administration of antibiotics which saves lives. In the case of more serious conditions, such as sepsis, treatment should be started within an hour of the diagnosis. Unfortunately, current tests often take days to complete, putting lives at risk.
Image: Colonies of Staphylococci
Dr. Ota Samek heads a Biophotonics and Optofluidics group at the Institute of Scientific Instruments within the Czech Academy of Sciences. The group has been using Raman spectroscopy to speed up the identification of bacterial infections and are hoping to introduce this method to hospitals as a tool for clinical diagnosis.
The team's initial study focused on using Raman spectroscopy to identify staphylococci strains from bacterial colonies grown on an agar plate. Using a Renishaw inVia™ Raman microscope, the researchers acquired Raman spectra for 277 different staphylococcal strains and were able to differentiate between 16 species of staphylococci with almost 100% accuracy. This led to further research on the two most common infection-causing species of staphylococci – S. aureus and S. epidermidis. The team found that Raman spectroscopy techniques enabled them to rapidly and reliably distinguish between the strains.
Dr. Samek said, “This method paves a way for fast separation of these two species even on a high number of samples and, therefore, it can also be potentially used in clinical diagnostics. It is supported by the advantages of using the inVia Raman instrument, which include speed, easy operation, reliability, and automation of experiments.”
The group's success in identifying strains of staphylococci using Raman spectroscopy inspired further studies into whether the technique could also be used to investigate bacterial biofilms. Biofilms provide microorganisms with their own microenvironment that helps them survive within a host organism. They can be found on objects such as catheters, cannulas, artificial heart valves and even contact lenses. In this study, the team selected bacterium Staphylococcus epidermis and yeast Candida parapsilosis and used the inVia Raman microscope to distinguish between biofilm-positive- and biofilm-negative-strains directly from colonies grown on agar plates.
Explaining the results of his research, Dr. Samek said We found that the overall accuracy was 98.9% for C. parapsilosis and 96.1% for S. epidermidis. These results suggest that Raman spectroscopy could be potentially used in detection of biofilm formation among tested microbes. Thus, clinicians can make their first decisions on antibiotic treatment based upon the knowledge of whether biofilm-forming microorganisms are present or not. This finding helps to establish a proper treatment for the patient.
Dr. Samek has been using Renishaw Raman instruments to study staphylococci since 2007 when he spent two years at Swansea University, sponsored by a Marie-Curie Intra-European Fellowship. He noted the strong relationships between Renishaw and Swansea University and this encouraged him to connect with Renishaw on his return to the Czech Republic. He concluded, After an excellent experience with Raman instrumentation at Swansea, it was an obvious decision for us to acquire a Renishaw system when we started our Raman-based lab in Brno.In our work we found the inVia Raman microscope very reliable for the long-term measurements of a large number of bacterial samples. Thus, reproducibility of the results could be guaranteed. We also appreciate the professional attitude of our Renishaw product manager in in the Czech Republic. This combination definitely helps to improve our enthusiasm for further lab work, mainly based on experiments using the inVia Raman microscope.

Image: Ota Samek
Dr. Samek and his team have published several papers on their research:
K.Rebrosova, M.Siler, O.Samek, F.Ruzicka, S.Bernatova, V.Hola, J.Jezek, P.Zemanek, J. Sokolova, P.Petras: "Rapid identification of staphylococci by Raman spectroscopy", Scientific Reports 7, 14846, 2017.
K. Rebrosovsa, M. Siler, O. Samek, F. Ruzicka, S. Bernatova, J. Jezek, P. Zemanek, V. Hola: "Differentiation between Staphylococcus aureus and Staphylococcus epidermidis strains using Raman spectroscopy", Future Microbiology 12, 881-890, 2017.
K. Rebroov, M. iler, O. Samek, F. Ruicka, S. Bernatov, J. Jeek, P. Zemnek, V. Hol, Identification of ability to form biofilm in Candida parapsilosis and Staphylococcus epidermidis by Raman spectroscopy. Future Microbiology 14, 509518, 2019
Photo Credit: An SEM image of a white blood cell phagocytizing four S. aureus bacteria. From the National Institute of Allergy and Infectious Diseases (NIAID)

Further reading
We have a whole range or articles, case studies and news stories about Raman spectroscopy.

About the inVia microscope
Discover more about how the inVia confocal microscope is suitable for your organisations applications.